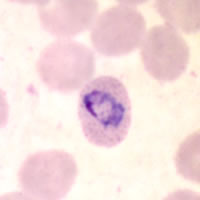
P. ovale rings in a thin blood smear

|
|
[Last Modified: ] |
|
|
|
| [Plasmodium
falciparum] [Plasmodium malariae] [Plasmodium ovale] [Plasmodium vivax] |
|
Plasmodium ovale: Ring Stage Parasites
Smears from patients:
Plasmodium ovale rings have sturdy cytoplasm and large chromatin dots. Red blood cells (RBCs) are normal to slightly enlarged (1 1/4 ×), may be round to oval, and are sometimes fimbriated. Schüffner's dots are visible under optimal conditions.
 |
|
| A | B |
A, B: P. ovale rings in thin blood smears. A shows fimbriation of the infected RBC. B shows Schüffner's dots.
 |
 |
| C | D |
C, D: Rings of P. ovale in thick blood smears.
|
||||||||